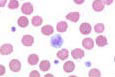

Chemotherapy Side Effects
Different chemotherapy drugs cause different
side effects, and some people may have very few. Cancer treatments cause
different reactions in different people and any reaction can vary from
treatment to treatment.
It may be helpful to remember that almost all
side effects are only short-term and will gradually disappear once the
treatment has stopped.

The main areas of your body that may be
affected by chemotherapy are those where normal cells rapidly divide and grow,
such as the lining of your mouth, the digestive system, your skin, hair and
bone marrow (the spongy material that fills the bones and produces new blood
cells).
Possible side effects of some chemotherapy drugs
|
Tiredness
Bone marrow
Alteration of kidney
function
Nausea and vomiting
Loss of appetite |
Diarrhoea
Constipation
Your mouth
Taste changes
Weakness |
Hair loss
Effects on the nervous
system
Changes in hearing
Skin changes
Effects on the nerves
|
Tiredness
While having chemotherapy and for some time afterwards you may feel
very tired (fatigued) and have a general feeling of weakness. It is
important to allow yourself plenty of time to rest.
 The
tiredness will ease off gradually once the chemotherapy has ended,
but some people find that they still feel tired for a year or more
afterwards. The
tiredness will ease off gradually once the chemotherapy has ended,
but some people find that they still feel tired for a year or more
afterwards.
Bone marrow
Chemotherapy can
reduce the number of blood cells produced by the bone marrow. Bone
marrow is a spongy material that fills the bones and contains stem
cells, which normally develop into the three different types of
blood cell.
The cells produced by bone marrow:
►white blood
cells are essential for fighting infections
►red blood cells contain haemoglobin to carry oxygen round the
body
►platelets help to clot the blood and prevent bleeding.
White blood cells
If the number of white cells in your blood is low you will be more likely to get
an infection as there are fewer white cells to fight off bacteria. If your
temperature goes up, or you suddenly feel unwell, even with a normal
temperature, contact your doctor or the hospital straight away. Most hospitals
consider a temperature above 38°C (100.5°F) to be high, although some hospitals
use a lower or higher temperature.
 Your
regular blood tests will also show the number of white cells in the blood. If
you get an infection when your white blood cell level is low you may need to
have antibiotics. Your
regular blood tests will also show the number of white cells in the blood. If
you get an infection when your white blood cell level is low you may need to
have antibiotics.
These may be given intravenously (into the vein) in the chemotherapy day unit or
as tablets which can be taken at home. You may need to be admitted to hospital
for the antibiotic treatment.
In some circumstances, drugs called growth factors can help your bone marrow to
make more white blood cells. Growth factors are special proteins, normally made
in the body, which can now be produced in the laboratory.
Blood cells are usually at their lowest level from 7 to14 days after the
chemotherapy treatment, although this will vary depending on the type of
chemotherapy.
Red blood cells
If the level of red blood cells (haemoglobin) in your blood is low you may
become very tired and lethargic. As the amount of oxygen being carried around
your body is lower, you may also become breathless.
These are all symptoms of anaemia - a lack of haemoglobin in the blood. People
with anaemia may also feel dizzy and light-headed, and have aching in their
muscles and joints.
During chemotherapy you will have regular blood tests to measure your
haemoglobin. A blood transfusion can be given if your haemoglobin is low. The
extra red cells in the blood transfusion will very quickly pick up the oxygen
from your lungs and take it around the body. You will feel more energetic and
any breathlessness will be eased.
Sometimes a drug called erythropoietin can be used to stimulate the bone marrow
to produce red blood cells more quickly. Erythropoietin is given as an injection
just under the skin of the thigh or abdomen, from one to five times a week.
Platelets Platelets
If the number of platelets in your blood is low you may bruise very easily and
may suffer from nosebleeds or bleed more heavily than usual from minor cuts or
grazes. If you do develop any unexplained bleeding or bruising you need to
contact your doctor or the hospital straight away, and you may need to be
admitted to hospital for a platelet transfusion.

A fluid containing platelets is given by drip into your blood. These platelets
will start to work immediately, to prevent bruising and bleeding.
Your regular blood tests will also be used to count the number of platelets in
your blood. If your platelets are low, take care to avoid injury - for example,
if you are gardening wear thick gloves.
Alteration of kidney function
Some chemotherapy drugs such as cisplatin and ifosfamide can cause damage to the
kidneys. In order to prevent kidney damage, fluids may be given by drip into
your vein for several hours before you have the treatment and your kidney
function will be carefully checked by blood tests before each treatment.
Nausea and vomiting
Some chemotherapy drugs can make you feel sick (nausea), or actually be sick
(vomit). Many people have no sickness, but for those who do there are now very
effective treatments to prevent and control it, so it is much less of a problem
than it was in the past.
If you do feel sick, it will usually start from a few minutes to several hours
after the chemotherapy, depending on the drugs you are having. The sickness may
last for a few hours or, rarely, for several days.
 Your
doctor can prescribe anti-sickness drugs (anti-emetics) to stop or reduce this
side effect. Anti-emetics may be given by injection with the chemotherapy and as
tablets to take at home afterwards. Your
doctor can prescribe anti-sickness drugs (anti-emetics) to stop or reduce this
side effect. Anti-emetics may be given by injection with the chemotherapy and as
tablets to take at home afterwards.
Steroids can also be helpful in reducing nausea and vomiting. Given in this way,
they often give a sense of well-being, as well as helping to reduce feelings of
sickness and loss of appetite.
Diarrhoea and constipation
Some chemotherapy drugs can affect the lining of the digestive system and this
may cause diarrhoea for a few days. Some chemotherapy drugs (or drugs given to
control side effects such as nausea) can cause constipation.
If you have any diarrhoea or constipation, or are worried about the effects of
chemotherapy on your digestive system, see your doctor or chemotherapy nurse to
discuss any problems you may have.
Your mouth
Some drugs can cause a sore mouth, which may lead to mouth ulcers. If this
happens it is usually about 5 to 10 days after the drugs are given and will
clear up within three to four weeks. Your doctor can prescribe mouthwashes to
help. The mouth ulcers can become infected, but your doctor can give you
treatment to help prevent or clear infection. Cleaning your teeth regularly and
gently with a soft toothbrush will help to keep your mouth clean.
If your mouth is very sore, gels, creams or pastes can be used to paint over the
ulcers to reduce the soreness. Your cancer specialist can tell you about these.
Taste changes
Chemotherapy can cause your taste to change; food may taste more salty, bitter
or metallic. Normal taste will come back after the chemotherapy treatment
finishes.
Your hair
Complete or partial hair loss can occur with some chemotherapy drugs and can be
very distressing. Some drugs cause no hair loss or the amount of hair lost is so
slight it is hardly noticeable.
Some chemotherapy can damage hair and make it brittle. If this happens the hair
may break off near the scalp a week or two after the chemotherapy has started. The amount of hair lost, if any, depends on the type of drug or combination of
drugs used, the dose given and the person's individual reaction to the drug. If
hair loss happens it usually starts within a few weeks of beginning treatment,
although very occasionally it can start within a few days. Underarm, body and
pubic hair may be lost as well. Some drugs also cause loss of the eyelashes and
eyebrows. If you do lose your hair as a result of chemotherapy, it will grow
back once you have finished your treatment. See
HAIR LOSS page
The amount of hair lost, if any, depends on the type of drug or combination of
drugs used, the dose given and the person's individual reaction to the drug. If
hair loss happens it usually starts within a few weeks of beginning treatment,
although very occasionally it can start within a few days. Underarm, body and
pubic hair may be lost as well. Some drugs also cause loss of the eyelashes and
eyebrows. If you do lose your hair as a result of chemotherapy, it will grow
back once you have finished your treatment. See
HAIR LOSS page
Skin changes
Some drugs can affect your skin. These may make your skin become dry or slightly
discoloured and may be made worse by swimming, especially if there is chlorine
in the water. Any rashes should be reported to your doctor.
The drugs may also make your skin more sensitive to sunlight, during and after
the treatment. Protect your skin from the sun by wearing a hat and sunglasses,
covering skin with loose clothing and using sunscreen cream on any exposed
areas.
Your nails
Your nails may grow more slowly and you may notice white lines appearing across
them. Sometimes the shape or colour of your nails may change: they may become
darker or paler. False nails or nail varnish can disguise white lines. Your
nails may also become more brittle and flaky.
Effects on the nerves
Some chemotherapy drugs can affect the nerves in the hands and feet. This can
cause tingling or numbness, or a sensation of pins and needles. This is known as
peripheral neuropathy. Let your doctor know if it occurs.
Usually it gradually reduces when the chemotherapy treatment ends but if it
becomes severe it can damage the nerves permanently. Your doctor will keep a
close check on you and may need to change the chemotherapy drug if the problem
is getting worse.
Effects on the nervous system
Some drugs can cause feelings of anxiety and restlessness, dizziness,
sleeplessness or headaches. Some people also find it hard to concentrate on
anything.
Changes in hearing
Some chemotherapy drugs can cause loss of the ability to hear high-pitched
sound. They can also cause a continuous noise in the ears known as tinnitus,
which can be very distressing. Let your doctor know if you notice any change in
your hearing.
Social life
You may be able to go to work and carry
on with your social activities as usual, but may need to take rests during the
day or shorten your working hours.
Some people feel very tired during
chemotherapy. This is quite normal and may be caused by the drugs themselves and
your body fighting the disease, or may simply be because you are not sleeping
well.
For someone who normally has a lot of
energy, feeling tired all the time can be very frustrating and difficult to cope
with. The hardest time may be towards the end of the course of chemotherapy.
Try to cut down on any unnecessary
activities and ask your family or friends to help you with jobs such as shopping
and housework. It is important not to fight your tiredness. Give yourself time
to rest and if you are still working see if it is possible to reduce your hours
while you are having treatment.
If you are having problems with
sleeping, your GP may be able to prescribe some mild sleeping tablets for you.
While you are having chemotherapy you
may find that you cannot do some of the things you used to take for granted. But
you needn't stop your social life completely.
Depending on how well you feel, there is
no reason to stop going out or visiting friends, especially if you can plan
ahead for social occasions. For example, if you are going out for the evening,
you could make sure that you get plenty of rest during the day so you have more
energy for the evening.
If you are planning to go out for a
meal, you may find it helpful to take anti-sickness tablets before you go and to
choose your food carefully from the menu.
If you have an important social event
(such as a wedding) coming up, discuss with your doctor whether your treatment
can be altered so that you can feel as well as possible for the occasion.
Alcohol
For most people, having the occasional alcoholic drink will not affect their
chemotherapy treatment, but it is best to check with your doctor beforehand.
Holidays and vaccinations
If you are going abroad on
holiday, it is important to remember that you should not have any 'live virus'
vaccines while you are having chemotherapy.
These include polio, measles, rubella
(German measles), MMR (the triple vaccine for measles, mumps and rubella), BCG
(tuberculosis), yellow fever and typhoid medicine. There are, however, vaccines
which you can have, if necessary.
If you are travelling abroad ask your
doctor whether you should have other vaccines such as diphtheria, tetanus, flu,
hepatitis B, hepatitis A, rabies, cholera or typhoid injection.
Sometimes people who have, or have had,
cancer can find it difficult to get travel insurance to travel abroad.
Will
chemotherapy affect my sex life?
Some people go through their chemotherapy
with their usual sex lives unaffected. On the other hand, some people find
that their sex lives are temporarily or permanently changed in some way due
to their treatment.Any
changes that occur are usually temporary, and should not have a long-term
effect on your sex life. For example, there may be times when you just feel
too tired, or perhaps not strong enough for the level of physical activity
you are used to during sex.
If your treatment is making you feel
sick, you may not want to have sex at all for a while. Anxiety may also play a large part in
putting you off sex. Often this anxiety may not seem directly related to
sex; you may be worried about your chances of surviving your cancer, or how
your family is coping with the illness, or about your finances. Stresses
like these can easily push everything else, including sex, to the back of
your mind.
Any such changes are usually
short-term and not serious. There is no medical reason to stop having sex at
any time during your course of chemotherapy. It is perfectly safe, and the
chemotherapy drugs themselves will have no long-term physical effects on
your ability to have and enjoy sexual activity. Any changes in your sex life are
unlikely to last long.
It is thought that chemotherapy drugs
cannot pass into semen or vaginal fluids. However, for people having
chemotherapy most hospitals advise the use of condoms during sexual activity
for up to a few days after the treatment has been given. This is to prevent
any possible problems for their partner.
It is important to take good
contraceptive precautions whilst having chemotherapy, as chemotherapy
drugs can harm the baby if pregnancy occurs. For this reason, your doctor will
advise you to use a reliable method of contraception (usually 'barrier'
methods - such as condoms or the cap) throughout your treatment and for
a few months afterwards.
The only exception may be women
whose chemotherapy has brought on an early menopause. These women will
experience symptoms usually associated with the menopause, which may
include dryness of the vagina and a decreased interest in sex.
If you are worried that the
chemotherapy could affect your sex life, try to discuss your worries
with your cancer specialist before your treatment starts. Your doctor
should be able to tell you about the side effects your treatment may
cause and you can then talk about the main effects of these, if any, on
your sex life.
You need to know about all aspects
of your treatment, and if sex is an important part of your life, it
matters that you should be fully aware of any possible changes. It may help if you can discuss
your feelings and any worries with your partner. Even though it is
unlikely that chemotherapy will cause any problems with sex, your
partner may still have some anxieties and may have been waiting for a
sign from you to show that it is all right to discuss them. Perhaps your
partner could join you if you decide you want to talk to your doctor.
Overcoming any problem, sexual or
otherwise, may seem like an uphill struggle when you are also trying to
come to terms with your cancer and cope with chemotherapy. Remember that
most side effects from chemotherapy that may affect your sex life, such
as tiredness or sickness, will gradually wear off once your treatment is
finished.
Will
chemotherapy make me infertile?
Unfortunately some chemotherapy
treatments may cause infertility. Infertility is the inability to become
pregnant or to father a child and may be temporary or permanent,
depending on the drugs that you are having.
It is strongly advised that you
discuss the risk of infertility fully with your doctor before you start
treatment. If you have a partner he or she will probably wish to join
you at this discussion so you can both be aware of all the facts and
have a chance to talk over your feelings and options for the future.
Although chemotherapy can reduce
fertility it is quite possible for a woman having chemotherapy to become
pregnant during the treatment. The side effects of chemotherapy, such as
sickness and diarrhoea, can make the pill less effective. Female
partners of a man having chemotherapy may also become pregnant.
Pregnancy should be avoided during chemotherapy in case the drugs harm
the baby.
Female fertility
Some drugs will have no effect on your fertility, but some may
temporarily or permanently stop your ovaries producing the eggs which
can be fertilised by the sperm during sex.
If this happens it means,
unfortunately, that you can no longer become pregnant and it will also
bring on symptoms normally associated with the change of life (the
menopause).
During chemotherapy your monthly
periods may become irregular and stop and you may have hot flushes, dry
skin and dryness of the vagina. Some women's ovaries will start
producing eggs again once the treatment ends. If this is the case, the
infertility will have been short-term. Your periods will return to
normal after the treatment finishes. This happens in about a third
of women. Usually, the younger you are, the more likely you are to have
normal periods again and still be able to have children once the
chemotherapy has ended.
Depending on the type of cancer
you have, your doctor may be able to prescribe hormone tablets to
help relieve the menopausal side effects. The hormones, unfortunately,
will not enable you to start producing eggs again and so cannot prevent
infertility.
Pregnancy and cancer
If you are pregnant before
your cancer is diagnosed and your chemotherapy starts, it is very
important to discuss with your doctor the pros and cons of continuing
with your pregnancy.
It is sometimes possible to
delay starting chemotherapy until after the baby is born, depending on
the type of cancer you have, the extent of the disease, how advanced the
pregnancy is and the particular chemotherapy you will be having.
You will need to talk to your
doctor about your pregnancy and be sure you are fully aware of all the
risks and alternatives before making any decisions.
Male fertility
Some chemotherapy drugs will have no effect at all on fertility, but
some may reduce the number of sperm produced or affect their ability to
reach and fertilise a woman's egg during sex.
Unfortunately, this means you
may no longer be able to father children. However, you will still be
able to get an erection and have an orgasm as you did before you started
your treatment.
You should use a reliable
barrier method of contraception all through your treatment.
If you have not completed your
family before you need to start chemotherapy, you may be able to bank
some of your sperm for later use.
If this is possible in your
case, you will be asked to produce several sperm samples over a few
weeks. These will then be frozen and stored so that they can be used
later to try to fertilise an egg and make your partner pregnant.
The pregnancy should then carry
on as normal. You may be charged a fee for sperm storage, and also
for the infertility treatment.
If the chemotherapy does cause
infertility, some men will remain infertile after their treatment has
stopped while others will find their sperm returns to normal levels and
their fertility comes back.
Sometimes it may take a few
years for fertility to return. Your doctor will be able to do a sperm
count for you when your treatment is over to check your fertility.
Teenage boys should also be
aware of the infertility risk so that, if possible, their sperm can be
stored for later years.
Your feelings about
infertility
Some people are devastated
when they discover that the treatment they need for their cancer will
also mean they can no longer have any children. If you had been planning
to have children in the future or to have more children to complete your
family, infertility will be very hard to come to terms with.
The sense of loss can be very
painful and distressing for people of all ages. Sometimes it can feel as
though you have actually lost a part of yourself.
You may feel less of a man or
less feminine because you can't have children. Women especially may be
distressed, and resentful that the drugs may cause bodily changes, such
as the menopause, which can further undermine their self-confidence.
People vary in their reactions
to the risk of infertility. Some people may shrug it off and feel that
dealing with the cancer is more important. Others may seem to accept the
news calmly when they start treatment and find that the impact doesn't
hit them until the treatment is over and they are sorting out their
lives again.
There is no right or wrong way
to react. You may want to discuss the risks and all your options with
your doctor before you start treatment. You may also need an opportunity
to talk to a trained counsellor about any strong emotions which threaten
to become too much for you.
Your partner will also need
special consideration in any discussions about fertility and future
plans. You may both need to speak to a professional counsellor or
therapist specialising in fertility problems. They can help you to come
to terms with your situation.
|



